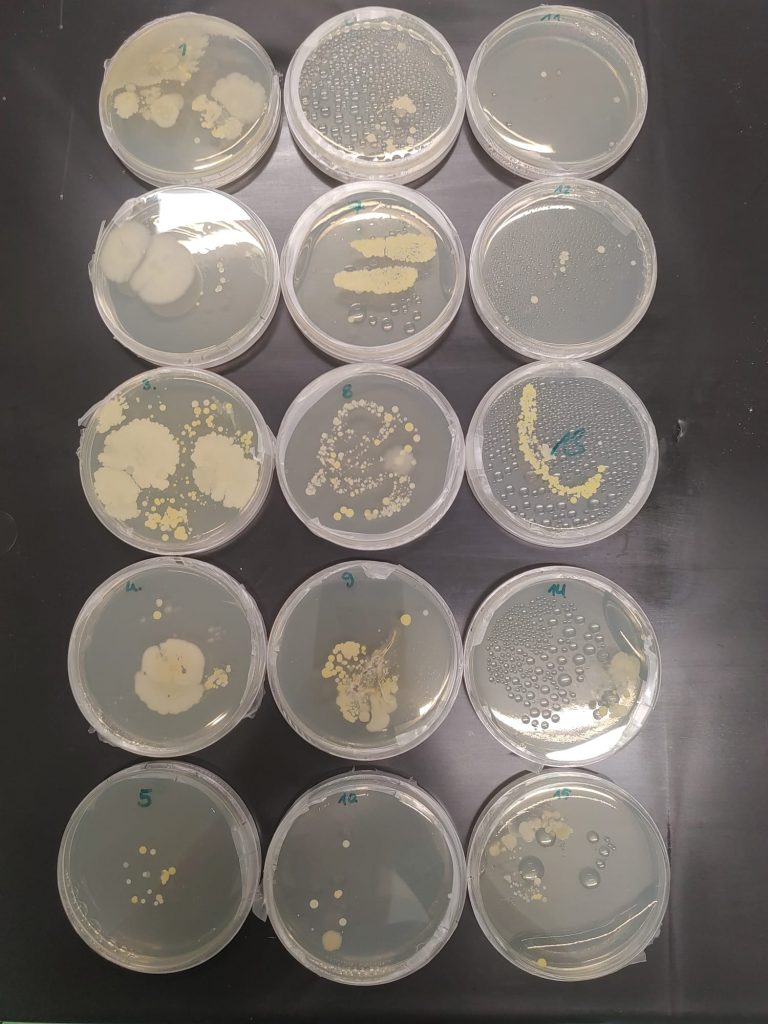

Am Tag der offenen Tür konnten Besucher testen, wie sehr ihre Hände und Alltagsgegenstände mit Mikroorganismen besiedelt sind. Dazu wurden die Objekte auf einen Nährboden gedrückt und dieser anschließend für mehrere Tage bei 37°C bebrütet. Die Ergebnisse sieht man hier: